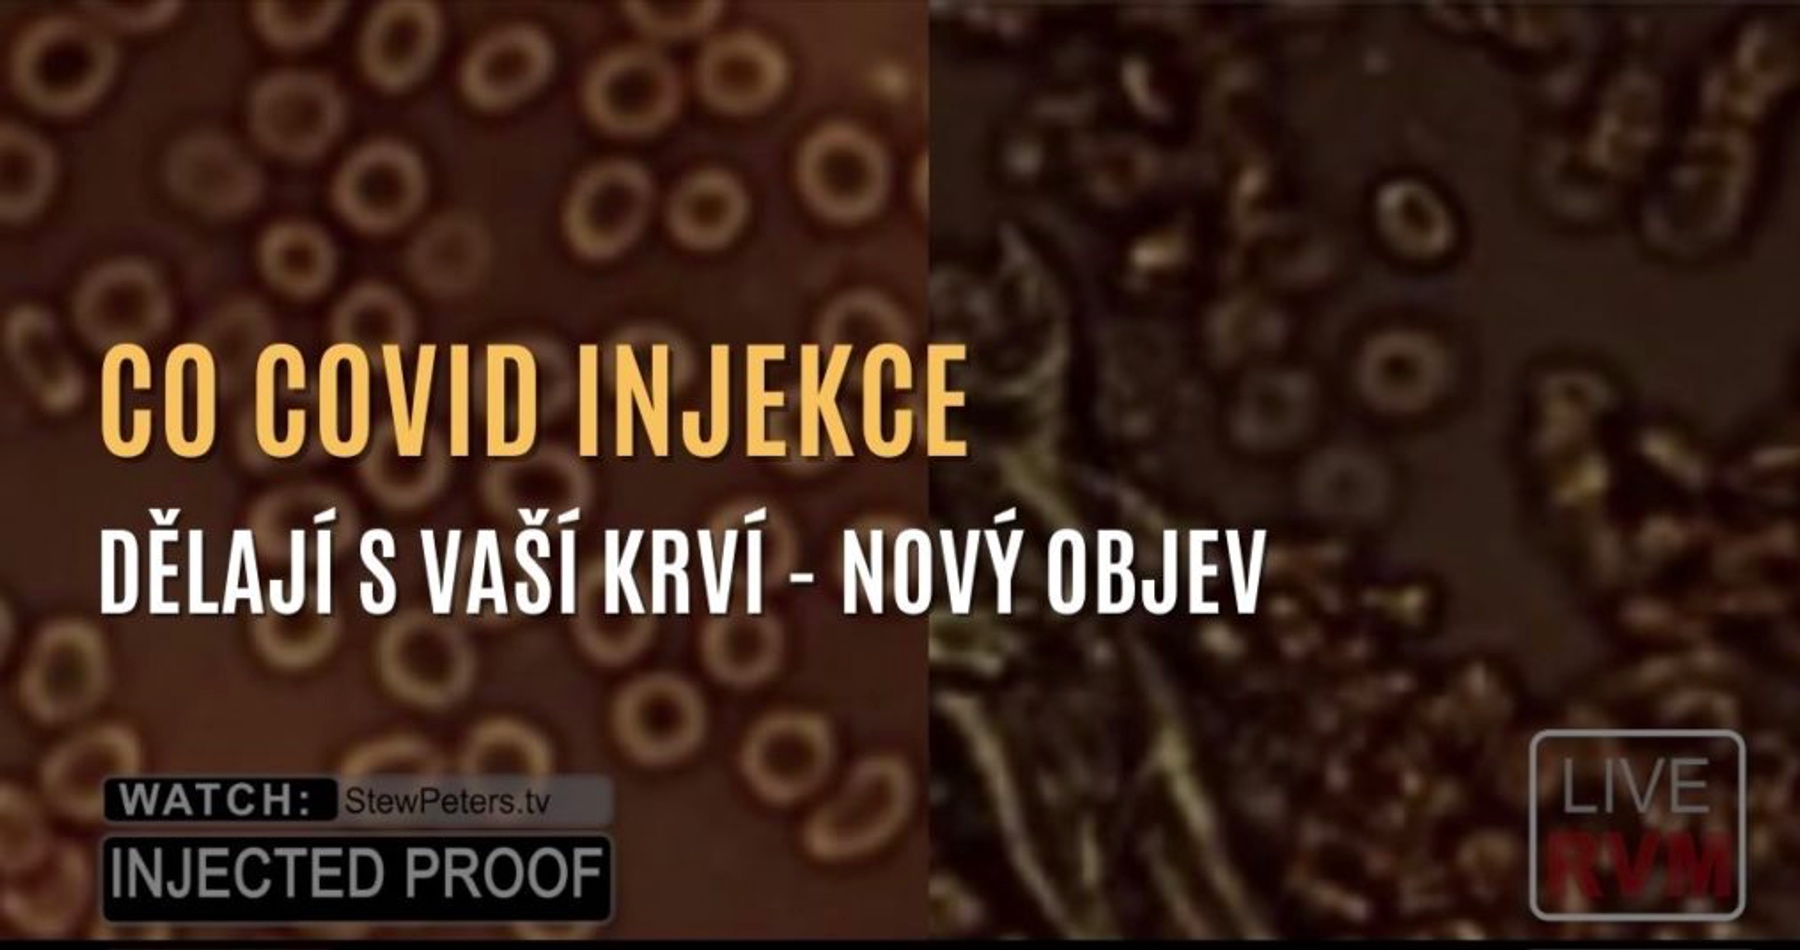

25. 05. 2026
|
Meniny má:
Urban, Vivien
VIDEO: Co covid injekce dělají s vaší krví? Dr. Jane Rubyová přináší šokující objev
11.08.2021 17:48
Dr. Jane Rubyová přináší zprávu a názorné snímky krve očkovaných osob v porovnání s neočkovanými osobami. Jak uvidíte, rozdíl je zásadní.
Video s českým dabingom:
Video s českými titulkami:
Prepis videa TU .
Zdroj: otevrisvoumysl.cz
VIDEO: „Irán rozohral s Donaldom Trumpom diabolskú partiu, v ktorej chce Západ už v lete zbaviť zásob ropy. Víťazom bude Čína,“ myslí si ekonomický analytik Lukáš Kovanda
VIDEO: ANTARKTÍDA – Tajomstvo z roku 1947, o ktorom sa muselo mlčať (ruský dokumentárny film)
VIDEO: Tajné expedície Ahnenerbe v Tibete, na Kaukaze, vo švédskej historickej provincii Bohuslän, na Kréte, ale aj v Antarktíde a inde vo svete alebo pátranie výskumného ústavu elitnej polovojenskej nacistickej organizácie SS po dôkazoch o pôvode árijskej rasy, nevysvetliteľné nálezy z obdobia 2. svetovej vojny, záhadná strata zhromaždených historických spisov v posledných dňoch Tretej ríše a 22 objavov nacistického Nemecka, ktoré spojenecké vlády po skončení vojny po roku 1945 okamžite utajili
VIDEO: Geopolitický analytik John Helmer o debakli Donalda Trumpa v Číne a o tom, ako ruský a čínsky prezident Vladimir Putin a Si Ťin-pching menia na planéte geopolitické mocenské pravidlá
VIDEO: „Judaizmus verzus sionizmus“. Antisionistický rabín Elhanan Beck vyhlásil, že štát Izrael nemá podľa Tóry právo na existenciu, a sionizmus označil za vzburu voči Bohu
VIDEO: „Neskáčte mi do reči, choďte do inej relácie Ruža pre nevestu alebo neviem kde.“ Ostrá debata Tibor Gašpar a Richard Takáč vs. Irena Bihariová a Zuzana Mesterová
VIDEO: „Vitajte v Izraeli, my sme pánmi tohto domu.“ Izraelský minister národnej bezpečnosti Itamar Ben Gvir zverejnil video, v ktorom sa vysmieva zajatým propalestínskym aktivistom. Tí kľačali s hlavami sklonenými k zemi, s rukami spútanými za chrbtom a so zaviazanými očami. Jednou zo zadržaných osôb bola aj Slovenka. Slovensko a ďalšie štáty sveta takéto šokujúce zaobchádzanie zo strany izraelských vojakov ostro odsúdili
VIDEO: „Progresívne Slovensko je strana klamárov a príživníkov,“ skonštatoval exposlanec Peter Pčolinský v rozhovore o svojom politickom projekte, o spomienkach na koaličné rady s Igorom Matovičom, o súčasných vzťahoch s Borisom Kollárom, o politickom programe PS, o mimovládke Marty Šimečkovej a o pravdepodobnosti, že jej občianske združenie okrem telefónnych účtov platilo aj náklady súvisiace so štúdiom Michala Šimečku v Oxforde. V interview hovoril aj o komunikačných poradcoch v PS, ktorých hlavnou úlohou je cielene usmerňovať a ovplyvňovať verejnú mienku. Komentoval aj tzv. „kladivo na korupciu“ a dianie okolo čurillovcov
VIDEO: Iránsky najvyšší duchovný vodca Modžtabá Chameneí zakázal vývoz vysoko obohateného uránu. „Dostaneme ho. Nepotrebujeme ho a ani ho nechceme, ale nemôžeme dovoliť, aby si ho nechali,“ vyhlásil prezident USA Donald Trump
VIDEO: „Mýtus o Veľkom Izraeli sa rúca.“ Bývalý analytik CIA Larry Johnson spochybnil oficiálnu verziu izraelských úradov, podľa ktorej bol masívny nočný výbuch v izraelskej zbrojovke Tomer sprevádzaný stúpajúcou ohnivou guľou a hríbovitým oblakom iba „kontrolovaným a vopred plánovaným testom“
VIDEO: „Irán nikdy neustúpi,“ vyhlásil profesor Dr. Mohammad Marandi s varovaním, že Blízky východ čelí najnebezpečnejšej fáze vojenského konfliktu
Eduard Chmelár: „To, čo sa deje okolo Mimi Šramovej a alternatívnych médií, je špinavý konkurenčný boj o príjmy z reklamy. Poviem vám viac, o čo tu ide…“
VIDEO: Bývalý americký vládny výskumník a kvantový fyzik Dr. Hal Puthoff tvrdí, že z vrakov havarovaných UFO boli zaistené štyri biologické druhy mimozemšťanov: „Siví, Nordici, Insektoidi a Reptiliáni“. To, čomu sa mnohí smiali, sa nakoniec ukazuje ako realita založená na svedectvách a dôkazoch
VIDEO: Americkí kresťanskí kazatelia sa obávajú plánovaného odhalenia pravdy o UFO a existencii vyspelých mimozemských civilizácií. Na stretnutí s predstaviteľmi amerických spravodajských služieb sa dozvedeli, že majú byť pripravení na to, že mnohí nábožensky založení ľudia budú šokovaní zverejnenými informáciami
Ruský exprezident Dmitrij Medvedev vysvetlil, prečo je Ukrajina skrachovaným štátom
VIDEO: Andrej Danko nalieha na výmenu ministra životného prostredia Tomáša Tarabu. Robert Fico mu odkázal, že rekonštrukcia vlády nepripadá do úvahy, a varoval ho pred stratou parlamentnej väčšiny. „Keď budeme mať 75 poslancov, tak sme skončili,“ vyhlásil premiér. Šéf SNS zúri, dvíha varovný prst a predsedu vlády označuje za nevyzretého politika
Stretnutia s poslucháčmi 2026: